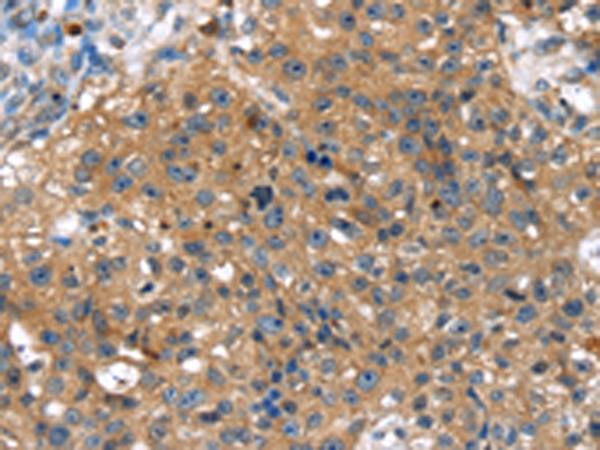
一抗

|
Background: |
This gene encodes a member of the T-box family of transcription factors. These transcription factors share a DNA-binding domain called the T-box, and play a role in several developmental processes including early embryonic cell fate and organogenesis. The encoded protein is a member of the T-box 1 subfamily. Mutations in this gene are thought to be a cause of isolated cleft lip with or without cleft palate. |
|
Applications: |
ELISA, IHC |
|
Name of antibody: |
TBX10 |
|
Immunogen: |
Fusion protein of human TBX10 |
|
Full name: |
T-box 10 |
|
Synonyms: |
TBX7; TBX13 |
|
SwissProt: |
O75333 |
|
ELISA Recommended dilution: |
2000-5000 |
|
IHC positive control: |
Human breast cancer |
|
IHC Recommend dilution: |
25-100 |

 購物車
購物車 幫助
幫助
 021-54845833/15800441009
021-54845833/15800441009